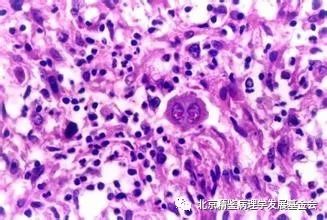
霍奇金淋巴瘤是良还是恶？

如今是谈癌色变的时代,那么说到某某瘤,大家印象里是恶性肿瘤还是良性肿瘤呢?一般来说医学分类里叫某某瘤的大多为良性,叫某某肉瘤或某某母细胞瘤(大部分)为恶性。那么霍奇金淋巴瘤是良性肿瘤还是恶性肿瘤呢?



霍奇金淋巴瘤是B细胞起源的独特的淋巴瘤。在患有淋巴瘤的群体中,霍奇金淋巴瘤占所有淋巴瘤的10%-20%,换言之十个患淋巴瘤的人里就有1-2个是霍奇金淋巴瘤。而且是多发于青少年与老年人。



首先要了解它的临床表征:
首发症状是局部淋巴结绝对无痛性的缓慢性的增大。淋巴结肿大,相邻的肿大淋巴结彼此粘连,融合,不活动。但是如果是早期,没有粘连,肿大的淋巴结也是可以活动的。
其次,它的特征有以下几点:
1、原发于淋巴结,由一个或一组开始由远及近的向周围淋巴结扩散。
2、镜下细胞成分多样,只有少数的肿瘤性大细胞(R-S细胞),占比0.1%-10%。不同个体,不同时期,R-S细胞占比都会有不同。
3、常伴有反应性炎细胞浸润与纤维化,细胞数量不等。
4、绝大部分R-S细胞与Ig基因克隆性重排有关。
5、很少累及骨髓。
它显微镜下能看到的病理变化是有R-S细胞的出现。R-S细胞有典型和非典型的(即R-S细胞的亚型)。经典的R-S细胞,体积巨大,直径在15-45微米之间,细胞质丰富,略微嗜酸性或嗜碱性,呈浅红色或浅紫色;细胞核圆或椭圆,巨大的双核或多核;有嗜酸性红染的核仁,与红细胞大小相当,核仁周围有空晕。双核的R-S细胞也被成为镜影细胞,由于核相对且对称。而非典型的R-S细胞即霍奇金细胞有以下几种:1、陷窝细胞, 2、LP细胞,3、木乃伊细胞。

接下来分别来阐述一下这三种霍奇金细胞。
1.陷窝细胞
顾名思义,有个陷窝,是由于甲醛固定组织后,胞质收缩,从而形成与周围细胞之前的透明间隙。细胞体积大,胞核染色质疏松,有一个或多个紫染的嗜碱性核仁。
2.LP细胞(爆米花细胞)
细胞体积大,分叶核,染色质稀少,有多个小的紫染的嗜碱性核仁,胞质淡染。
3.木乃伊细胞(干尸细胞)
变性凋亡的R-S细胞,核固缩强嗜碱性,胞质嗜酸性。




介绍了以上四种R-S细胞,那么来说说,出现这几种细胞的不同的霍奇金淋巴瘤的类别,即组织学分型。霍奇金淋巴瘤分为结节性淋巴细胞为主型霍奇金淋巴瘤,经典型霍奇金淋巴瘤。
结节性淋巴细胞为主型霍奇金淋巴瘤:这一种类型的淋巴瘤,在国内少见,而在欧美国家多见。患者多为中年男性。镜检时,多见的是LP细胞,即爆米花细胞。瘤细胞呈现CD20与CD79a阳性,且未被EB病毒感染。这种淋巴瘤,预后是极好的。主要的临床表现是颈部和腋下的淋巴结肿大。
经典型霍奇金淋巴瘤:国内多见,呈双峰形发病,15-35岁和大于50岁的人群高发。15-35岁这个区间患病的更多些。这一肿瘤被细分为四个亚型,结节硬化型,混合细胞型,富于淋巴细胞型,淋巴细胞减少型。
1.结节硬化型:
这种亚型最为常见,占比40%-70%,多见于青年女性,15-34岁,EBV感染率低。霍奇金细胞为陷窝细胞为主,好发于颈部,锁骨上,纵膈淋巴结,以纵膈淋巴结肿大造成巨大肿块为最危险的情况。瘤变淋巴结中,有大小不一的胶原纤维束构成的结节,中性粒与嗜酸性粒细胞较多。
2.混合细胞型:
较常见。老年男性多发,常有EBV病毒感染。霍奇金细胞为R-S细胞较多见。淋巴结结构被破坏,肿瘤细胞与炎细胞混杂。当发生混合细胞型霍奇金淋巴瘤,常伴有系统性症状,且累及脾脏与腹腔淋巴结。
3.富于淋巴细胞型:
该种类型较少见,老年群体中多发。瘤变组织中有大量反应性淋巴细胞。存在R-S细胞,炎性细胞与浆细胞少见。约40%的病例伴EBV感染,但该型预后较好。
4.淋巴细胞减少型:
该亚型极少见,瘤变组织中淋巴细胞极少,有大量R-S细胞或多边形瘤细胞。好发于HIV阳性患者,且EBV感染阳性率约100%。该型预后最差。

那么我们知道了这些分型,那最最重要的就是诊断标准和预后处理了。
在临床上诊断标准,金指标永远是病理科检出的R-S细胞。但是霍奇金淋巴瘤很奇怪,大部分的情况是它的瘤细胞很大,而数量却很少,且变异型瘤细胞多,所以穿刺的时候,有较大的漏诊率,那么就是要免疫组化等方法来辅助诊断。几乎所有的霍奇金淋巴瘤的病例中,CD30呈阳性。75%-85%病例CD15阳性,95%病例PAX5/BSAP阳性。以上的阳性可以用于霍奇金淋巴瘤的诊断。
那么上文说到霍奇金淋巴瘤是恶性肿瘤,是不是很多人听到就感觉不好,要遭殃?
不不不,千万不能这么想。现代的医学在不断地发展,虽然它是恶性肿瘤,但是相比起癌症之王,人们只要做到早发现早治疗,它还是可爱许多的——霍奇金淋巴瘤的预后较好。根据它的分期来选择治疗方案。上文所述霍奇金淋巴瘤是绝对无痛性的持续性增长,当人们发现自己淋巴结突然不痛不痒地长了一大块,就噌噌噌地往医院跑,发现的早,还是在一期,及早进行放化疗,治愈率高达90%。
它的分期如下:
-
一期是病变一组淋巴结或者一个结外器官/部位;
-
二期是局限于同侧的两组及以上,或蔓延至相临结外器官/部位;
-
三期两侧都有累及,或再加上一个结外器官/部位;
-
四期弥漫性累及。但即使是进展期,积极治疗后,也有50%-75%的五年生存期,所以即使霍奇金淋巴瘤是恶性肿瘤,但预后还是较为良好的。

